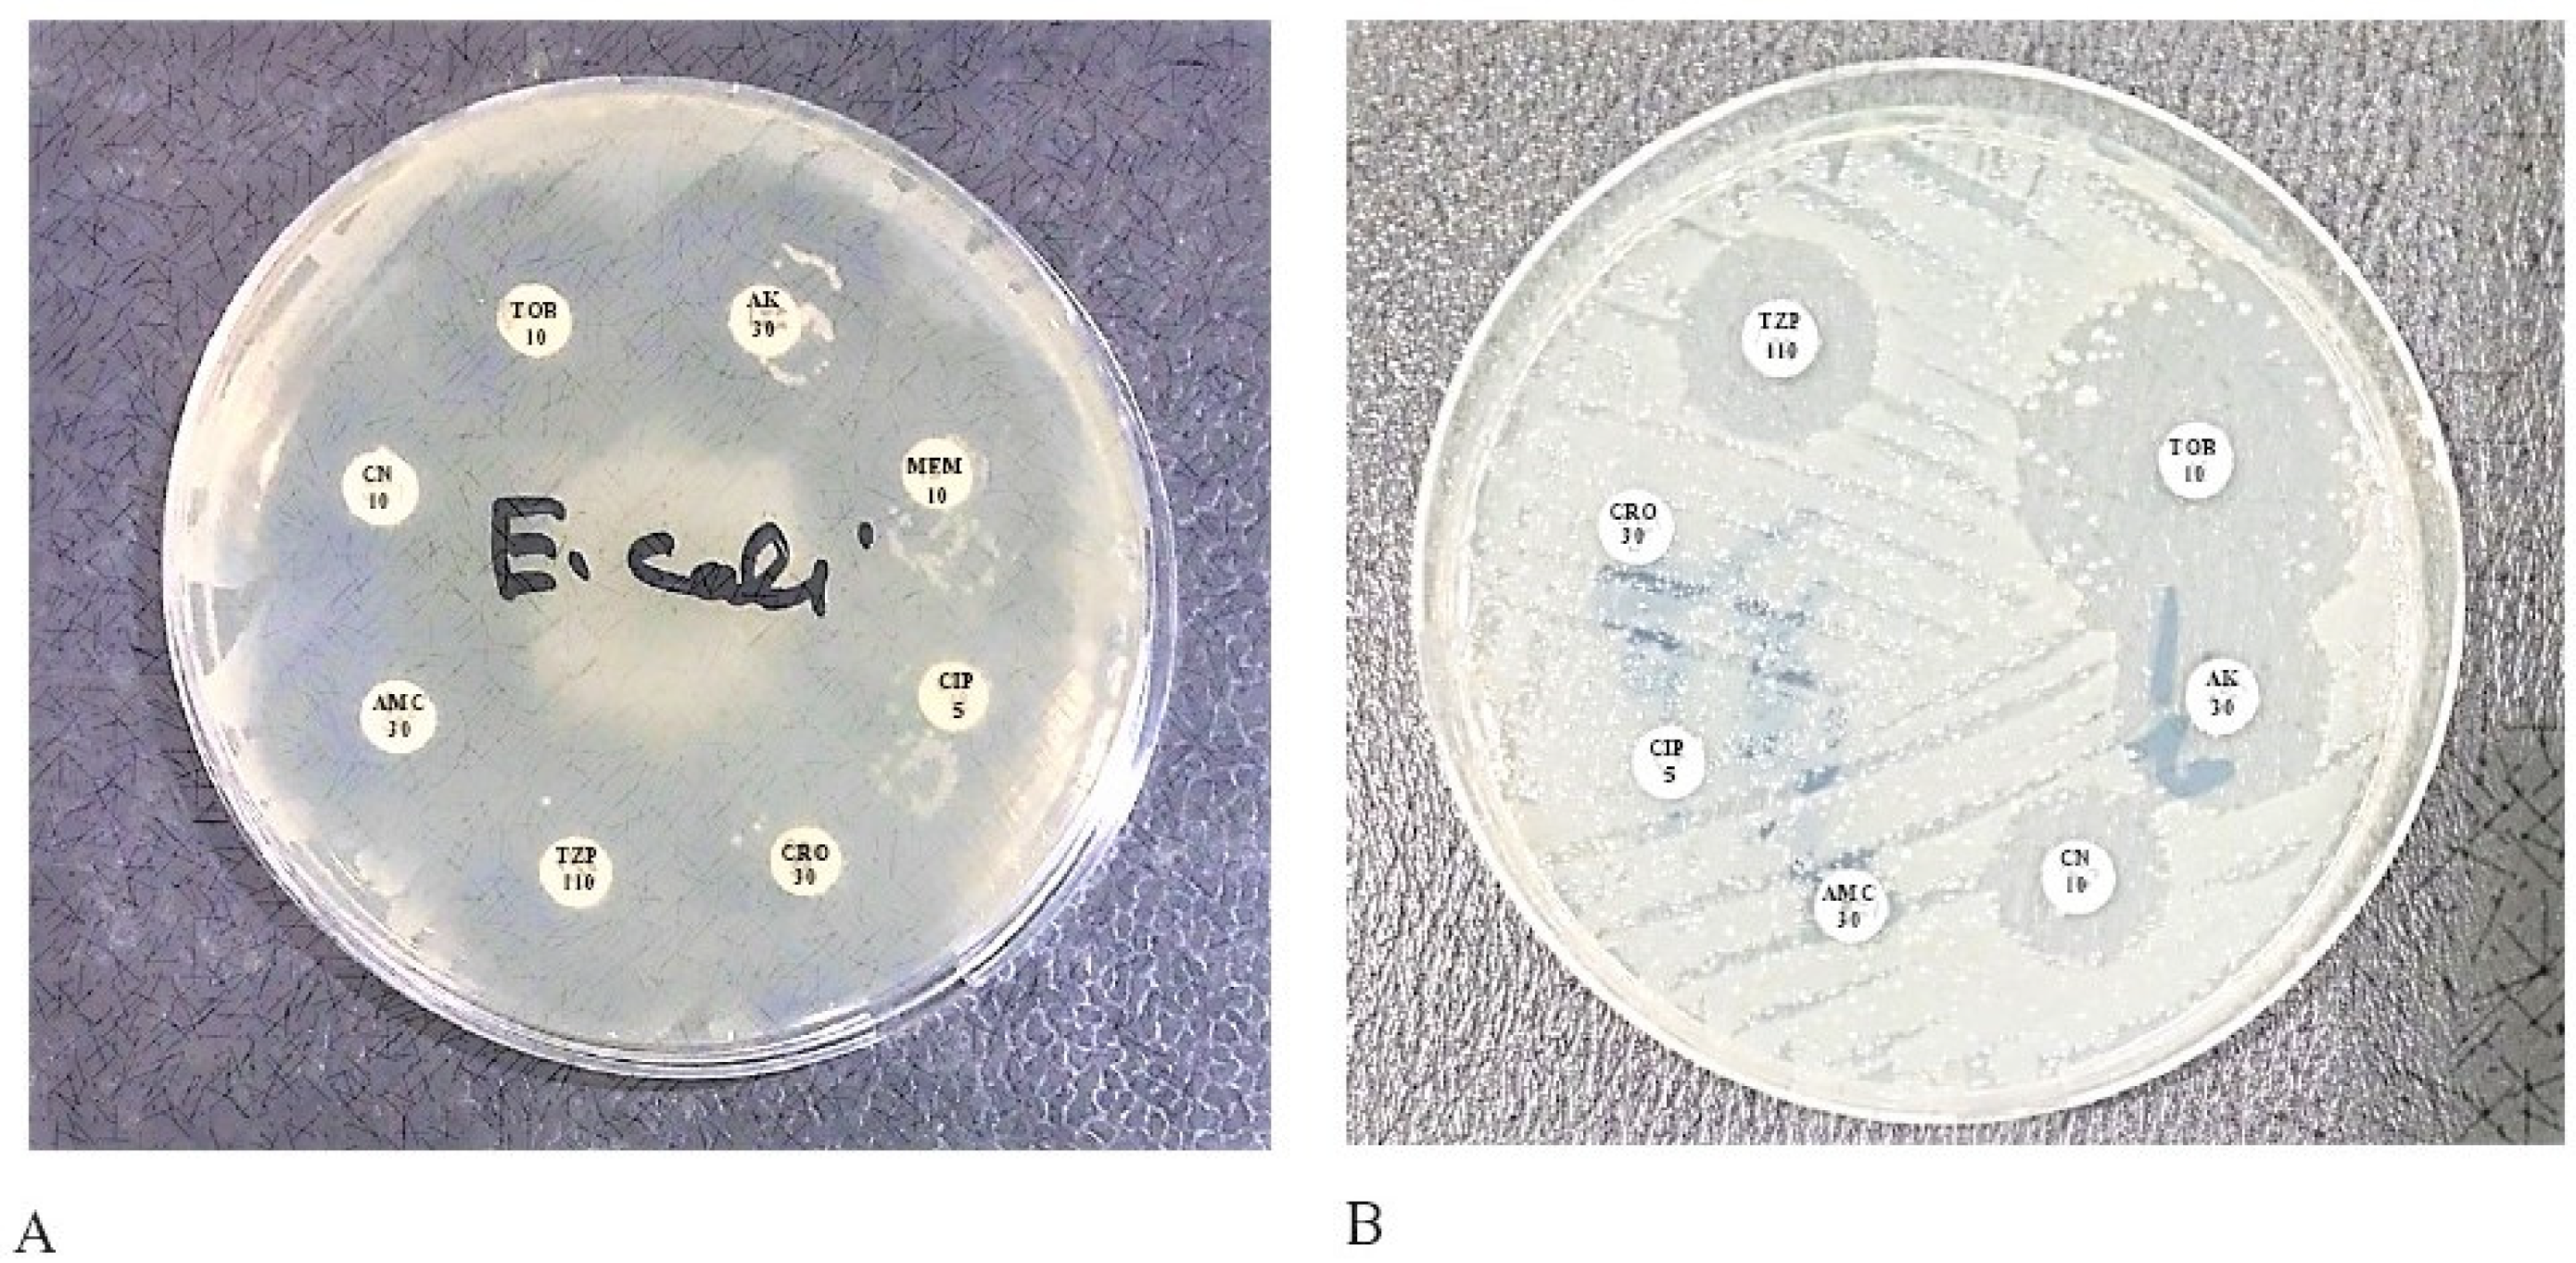
Pharmaceuticals 15 01426 g001 Pharmaceuticals 15 01426 g001

Heavy Metal (Arsenic) Induced Antibiotic Resistance among Extended-Spectrum β-Lactamase (ESBL) Producing Bacteria of Nosocomial Origin
Abstract
1. Introduction
2. Results
The Phenotypic Confirmatory Test for the Synthesis of Extended-Spectrum Beta-Lactamase Was as Follows
3. Discussion
4. Materials and Methods
4.1. Collection of Bacterial Isolates
4.2. Isolation and Re-Identification of Bacterial Isolates
4.3. Antibiotic Susceptibility Testing (AST) by the Kirby Bauer Disk Diffusion Method
4.4. The Double Disc Synergy Test (Phenotypic Confirmation Test)
4.5. Heavy Metals Susceptibility Pattern
4.6. Statistical Analysis
5. Conclusions
Author Contributions
Funding
Institutional Review Board Statement
Informed Consent Statement
Data Availability Statement
Acknowledgments
Conflicts of Interest
References
- Hutchings, M.I.; Truman, A.W.; Wilkinson, B. Antibiotics: Past, present and future. Curr. Opin. Microbiol. 2019, 51, 72–80. [Google Scholar] [CrossRef] [PubMed]
- Zeb, S.; Mushtaq, M.; Ahmad, M.; Saleem, W.; Rabaan, A.A.; Naqvi, B.S.Z.; Garout, M.; Aljeldah, M.; Al Shammari, B.R.; Al Faraj, N.J. Self-Medication as an Important Risk Factor for Antibiotic Resistance: A Multi-Institutional Survey among Students. Antibiotics 2022, 11, 842. [Google Scholar] [CrossRef] [PubMed]
- Pachori, P.; Gothalwal, R.; Gandhi, P. Emergence of antibiotic resistance Pseudomonas aeruginosa in intensive care unit; a critical review. Genes & diseases 2019, 6, 109–119. [Google Scholar]
- Rabaan, A.A.; Alhumaid, S.; Mutair, A.A.; Garout, M.; Abulhamayel, Y.; Halwani, M.A.; Alestad, J.H.; Bshabshe, A.A.; Sulaiman, T.; AlFonaisan, M.K. Application of Artificial Intelligence in Combating High Antimicrobial Resistance Rates. Antibiotics 2022, 11, 784. [Google Scholar] [CrossRef] [PubMed]
- Kovalakova, P.; Cizmas, L.; McDonald, T.J.; Marsalek, B.; Feng, M.; Sharma, V.K. Occurrence and toxicity of antibiotics in the aquatic environment: A review. Chemosphere 2020, 251, 126351. [Google Scholar] [CrossRef]
- Ahmed, N.; Khan, M.; Saleem, W.; Karobari, M.I.; Mohamed, R.N.; Heboyan, A.; Rabaan, A.A.; Mutair, A.A.; Alhumaid, S.; Alsadiq, S.A. Evaluation of bi-lateral co-infections and antibiotic resistance rates among COVID-19 patients. Antibiotics 2022, 11, 276. [Google Scholar] [CrossRef]
- Catalano, A.; Iacopetta, D.; Ceramella, J.; Scumaci, D.; Giuzio, F.; Saturnino, C.; Aquaro, S.; Rosano, C.; Sinicropi, M.S. Multidrug resistance (MDR): A widespread phenomenon in pharmacological therapies. Molecules 2022, 27, 616. [Google Scholar] [CrossRef]
- Ben, Y.; Fu, C.; Hu, M.; Liu, L.; Wong, M.H.; Zheng, C. Human health risk assessment of antibiotic resistance associated with antibiotic residues in the environment: A review. Environ. Res. 2019, 169, 483–493. [Google Scholar] [CrossRef]
- Chokshi, A.; Sifri, Z.; Cennimo, D.; Horng, H. Global contributors to antibiotic resistance. J. Glob. Infect. Dis. 2019, 11, 36. [Google Scholar]
- Ahmed, N.; Khalid, H.; Mushtaq, M.; Basha, S.; Rabaan, A.A.; Garout, M.; Halwani, M.A.; Al Mutair, A.; Alhumaid, S.; Al Alawi, Z. The Molecular Characterization of Virulence Determinants and Antibiotic Resistance Patterns in Human Bacterial Uropathogens. Antibiotics 2022, 11, 516. [Google Scholar] [CrossRef]
- Bergšpica, I.; Kaprou, G.; Alexa, E.A.; Prieto, M.; Alvarez-Ordóñez, A. Extended spectrum β-lactamase (ESBL) producing Escherichia coli in pigs and pork meat in the European Union. Antibiotics 2020, 9, 678. [Google Scholar] [CrossRef]
- Widodo, A.; Effendi, M.H.; Khairullah, A.R. Extended-spectrum beta-lactamase (ESBL)-producing Eschericia coli from livestock. Sys. Rev. Pharm. 2020, 11, 382–392. [Google Scholar]
- Tamma, P.D.; Aitken, S.L.; Bonomo, R.A.; Mathers, A.J.; van Duin, D.; Clancy, C.J. Infectious Diseases Society of America 2022 Guidance on the Treatment of Extended-Spectrum β-lactamase Producing Enterobacterales (ESBL-E), Carbapenem-Resistant Enterobacterales (CRE), and Pseudomonas aeruginosa with Difficult-to-Treat Resistance (DTR-P. aeruginosa). Clin. Infect. Dis. 2022, 72, e169–e183. [Google Scholar]
- Davin-Regli, A.; Lavigne, J.-P.; Pagès, J.-M. Enterobacter spp.: Update on taxonomy, clinical aspects, and emerging antimicrobial resistance. Clin. Microbiol. Rev. 2019, 32, e00002–e00019. [Google Scholar] [CrossRef]
- Palmeira, J.D.; Ferreira, H.M.N. Extended-spectrum beta-lactamase (ESBL)-producing Enterobacteriaceae in cattle production–a threat around the world. Heliyon 2020, 6, e03206. [Google Scholar] [CrossRef]
- Carcione, D.; Siracusa, C.; Sulejmani, A.; Leoni, V.; Intra, J. Old and new beta-lactamase inhibitors: Molecular structure, mechanism of action, and clinical Use. Antibiotics 2021, 10, 995. [Google Scholar] [CrossRef]
- Safavi, M.; Bostanshirin, N.; Hajikhani, B.; Yaslianifard, S.; van Belkum, A.; Goudarzi, M.; Hashemi, A.; Darban-Sarokhalil, D.; Dadashi, M. Global genotype distribution of human clinical isolates of New Delhi metallo-β-lactamase-producing Klebsiella pneumoniae; A systematic review. J. Glob. Antimicrob. Resist. 2020, 23, 420–429. [Google Scholar] [CrossRef]
- Kadri, S.S. Key takeaways from the US CDC’s 2019 antibiotic resistance threats report for frontline providers. Crit. Care Med. 2020. [Google Scholar] [CrossRef]
- Abrar, S.; Ain, N.U.; Liaqat, H.; Hussain, S.; Rasheed, F.; Riaz, S. Distribution of blaCTX− M, blaTEM, blaSHV and blaOXA genes in extended-spectrum-β-lactamase-producing clinical isolates: A three-year multi-center study from Lahore, Pakistan. Antimicrob. Resist. Infect. Control 2019, 8, 1–10. [Google Scholar] [CrossRef]
- Hayat, K.; Jamshed, S.; Rosenthal, M.; Haq, N.U.; Chang, J.; Rasool, M.F.; Malik, U.R.; Rehman, A.U.; Khan, K.M.; Fang, Y. Understanding of Pharmacy Students towards Antibiotic Use, Antibiotic Resistance and Antibiotic Stewardship Programs: A Cross-Sectional Study from Punjab, Pakistan. Antibiotics 2021, 10, 66. [Google Scholar] [CrossRef]
- Khan, F.; Mallhi, T.; Khan, F.; Hayat, K.; Rehman, A.; Shah, S.; Khan, Z.; Khan, Y.; Ahmad, T.; Gudi, S. Evaluation of Consumers Perspective on the Consumption of Antibiotics, Antibiotic Resistance, and Recommendations to Improve the Rational use of Antibiotics: An Exploratory Qualitative Study From Post-Conflicted Region of Pakistan. Front. Pharmacol. 2022, 13, 881243. [Google Scholar] [CrossRef] [PubMed]
- Verschuuren, T.; Van Hout, D.; Arredondo-Alonso, S.; Fluit, A.; Reuland, E.; Top, J.; Schürch, A.; Bosch, T.; Bonten, M.; Kluytmans, J. Comparative genomics of ESBL-producing Escherichia coli (ESBL-Ec) reveals a similar distribution of the 10 most prevalent ESBL-Ec clones and ESBL genes among human community faecal and extra-intestinal infection isolates in the Netherlands (2014–17). J. Antimicrob. Chemother. 2021, 76, 901–908. [Google Scholar] [CrossRef] [PubMed]
- Saravanan, M.; Ramachandran, B.; Barabadi, H. The prevalence and drug resistance pattern of extended spectrum β–lactamases (ESBLs) producing Enterobacteriaceae in Africa. Microb. Pathog. 2018, 114, 180–192. [Google Scholar] [CrossRef] [PubMed]
- Pandit, R.; Awal, B.; Shrestha, S.S.; Joshi, G.; Rijal, B.P.; Parajuli, N.P. Extended-spectrum β-lactamase (ESBL) genotypes among multidrug-resistant uropathogenic Escherichia coli clinical isolates from a teaching hospital of Nepal. Interdiscip. Perspect. Infect. Dis. 2020, 2020, 6525826. [Google Scholar] [CrossRef] [PubMed]
- Qamar, A.; Ismail, T.; Akhtar, S. Prevalence and antibiotic resistance of Salmonella spp. in South Punjab-Pakistan. PLoS ONE 2020, 15, e0232382. [Google Scholar] [CrossRef]
- Khan, G.A.; Berglund, B.; Khan, K.M.; Lindgren, P.-E.; Fick, J. Occurrence and abundance of antibiotics and resistance genes in rivers, canal and near drug formulation facilities–a study in Pakistan. PLoS ONE 2013, 8, e62712. [Google Scholar] [CrossRef]
- Sair, A.T.; Khan, Z.A. Prevalence of antibiotic and heavy metal resistance in Gram negative bacteria isolated from rivers in northern P akistan. Water Environ. J. 2018, 32, 51–57. [Google Scholar] [CrossRef]
- Shah, S.Q.; Colquhoun, D.J.; Nikuli, H.L.; Sørum, H. Prevalence of antibiotic resistance genes in the bacterial flora of integrated fish farming environments of Pakistan and Tanzania. Environ. Sci. Technol. 2012, 46, 8672–8679. [Google Scholar] [CrossRef]
- Hubeny, J.; Harnisz, M.; Korzeniewska, E.; Buta, M.; Zieliński, W.; Rolbiecki, D.; Giebułtowicz, J.; Nałęcz-Jawecki, G.; Płaza, G. Industrialization as a source of heavy metals and antibiotics which can enhance the antibiotic resistance in wastewater, sewage sludge and river water. PLoS ONE 2021, 16, e0252691. [Google Scholar] [CrossRef]
- Baquero, F.; Martínez, J.-L.; Cantón, R. Antibiotics and antibiotic resistance in water environments. Curr. Opin. Biotechnol. 2008, 19, 260–265. [Google Scholar] [CrossRef]
- Becerra-Castro, C.; Machado, R.A.; Vaz-Moreira, I.; Manaia, C.M. Assessment of copper and zinc salts as selectors of antibiotic resistance in Gram-negative bacteria. Sci. Total Environ. 2015, 530, 367–372. [Google Scholar] [CrossRef]
- Deredjian, A.; Colinon, C.; Brothier, E.; Favre-Bonté, S.; Cournoyer, B.; Nazaret, S. Antibiotic and metal resistance among hospital and outdoor strains of Pseudomonas aeruginosa. Res. Microbiol. 2011, 162, 689–700. [Google Scholar] [CrossRef]
- Dandachi, I.; Chaddad, A.; Hanna, J.; Matta, J.; Daoud, Z. Understanding the epidemiology of multi-drug resistant gram-negative bacilli in the Middle East using a one health approach. Front. Microbiol. 2019, 10, 1941. [Google Scholar] [CrossRef]
- Nguyen, C.C.; Hugie, C.N.; Kile, M.L.; Navab-Daneshmand, T. Association between heavy metals and antibiotic-resistant human pathogens in environmental reservoirs: A review. Front. Environ. Sci. Eng. 2019, 13, 1–17. [Google Scholar] [CrossRef]
- Dweba, C.C.; Zishiri, O.T.; El Zowalaty, M.E. Methicillin-resistant Staphylococcus aureus: Livestock-associated, antimicrobial, and heavy metal resistance. Infect. Drug Resist. 2018, 11, 2497. [Google Scholar] [CrossRef]
- Subramaniam, G.; Girish, M. Antibiotic resistance—A cause for reemergence of infections. Indian J. Pediatrics 2020, 87, 937–944. [Google Scholar] [CrossRef]
- Clinical and Laboratory Standards Institute. Performance Standards for Antimicrobial Susceptibility Testing, 28th ed.; CLSI Supplement M100; Clinical and Laboratory Standards Institute: Wayne, PA, USA, 2020. [Google Scholar]
- Akinbowale, O.L.; Peng, H.; Grant, P.; Barton, M.D. Antibiotic and heavy metal resistance in motile aeromonads and pseudomonads from rainbow trout (Oncorhynchus mykiss) farms in Australia. Int. J. Antimicrob. Agents 2007, 30, 177–182. [Google Scholar] [CrossRef]

| Characteristics | Frequency (n) | Percentage (%) | p-Value | |
|---|---|---|---|---|
| Type of specimens | Wound | 63 | 21 | 0.002 |
| Urine | 112 | 37.3 | ||
| Blood | 43 | 14.3 | ||
| Pus | 49 | 16.3 | ||
| Aspirate | 33 | 11 | ||
| Clinical isolate | Enterobacter spp. | 18 | 6 | 0.008 |
| Proteus mirabilis | 21 | 7 | ||
| P. aeruginosa | 32 | 10.6 | ||
| Klebsiella spp. | 57 | 19 | ||
| E. coli | 172 | 57.3 | ||
| Age (Years) | 18–23 | 63 | 21 | 0.002 |
| 23–28 | 112 | 37.3 | ||
| 28–33 | 43 | 14.3 | ||
| 33–38 | 49 | 16.3 | ||
| Gender | Male | 189 | 63 | 0.003 |
| Female | 111 | 37 | ||
| Enrollment | Indoor Patients | 204 | 68 | |
| Outdoor Patients | 96 | 32 | ||
| Antibiogram | Disc Contents | E. coli (n = 172) | Klebsiella Spp. (n = 57) | P. aeruginosa (n = 32) | Enterobacter Spp. (n = 18) | Proteus mirabilis (n = 21) |
|---|---|---|---|---|---|---|
| Ampicillin | 10 µg | 93.1 | 96.3 | 91 | 87 | 92 |
| Amikacin | 30 µg | 82 | 87.3 | 79.5 | 87 | 74 |
| Ceftriaxone | 30 µg | 75 | 82 | 68 | 77 | 96 |
| Cefuroxime | 30 µg | 97 | 92.4 | 92 | 90 | 97 |
| Chloramphenicol | 30 µg | 99 | 97 | 77 | 98 | 92 |
| Ciprofloxacin | 5 µg | 94 | 96 | 93.5 | 89.2 | 98 |
| Gentamicin | 10 µg | 93.5 | 88 | 91.2 | 83.5 | 99 |
| Imipenem | 10 µg | 91.5 | 92.2 | 97 | 99 | 81.5 |
| Meropenem | 10 µg | 90 | 98 | 99 | 90.5 | 77 |
| Tetracycline | 30 µg | 92.7 | 91.3 | 92 | 89.2 | 99 |
| Levofloxacin | 50 µg | 89.5 | 97 | 96 | 99 | 92.5 |
| Tobramycin | 10 µg | 92 | 98 | 98.5 | 93.5 | 98 |
| Fusidic acid | 10 µg | 91 | 88.5 | 99 | 90 | 97 |
| Cefixime | 5 µg | 88 | 99 | 98 | 99 | 87.5 |
| Colistin | 0 | 0 | 0 | 0 | 0 | 0 |
| Polymyxin B | 0 | 0 | 0 | 0 | 0 | 0 |
| Antibiogram | Heavy Metals Concentration | E. coli (n = 172) | Klebsiella Spp. (n = 57) | P. aeruginosa (n = 32) | Enterobacter Spp. (n = 18) | Proteus mirabilis (n = 21) |
|---|---|---|---|---|---|---|
| Ampicillin | 1.25 g/mL | 100 | 100 | 100 | 96 | 100 |
| Amikacin | 100 | 100 | 100 | 100 | 88 | |
| Ceftriaxone | 100 | 78 | 89 | 84 | 100 | |
| Cefuroxime | 92 | 100 | 100 | 100 | 100 | |
| Chloramphenicol | 100 | 100 | 73 | 100 | 100 | |
| Ciprofloxacin | 89 | 100 | 100 | 100 | 100 | |
| Gentamicin | 100 | 97 | 100 | 97 | 100 | |
| Imipenem | 86 | 100 | 100 | 100 | 98 | |
| Meropenem | 100 | 83 | 100 | 100 | 83 | |
| Tetracycline | 83 | 100 | 93 | 96 | 100 | |
| Levofloxacin | 100 | 97 | 100 | 97 | 100 | |
| Tobramycin | 93 | 91 | 100 | 100 | 100 | |
| Fusidic acid | 100 | 100 | 100 | 100 | 100 | |
| Cefixime | 100 | 100 | 100 | 100 | 100 | |
| Colistin | 32 | 23 | 56 | 33 | 12 | |
| Polymyxin B | 47 | 18 | 42 | 13 | 16 |
Publisher’s Note: MDPI stays neutral with regard to jurisdictional claims in published maps and institutional affiliations. |
© 2022 by the authors. Licensee MDPI, Basel, Switzerland. This article is an open access article distributed under the terms and conditions of the Creative Commons Attribution (CC BY) license (https://creativecommons.org/licenses/by/4.0/).
Share and Cite
Ahmed, N.; Tahir, K.; Aslam, S.; Cheema, S.M.; Rabaan, A.A.; Turkistani, S.A.; Garout, M.; Halwani, M.A.; Aljeldah, M.; Al Shammari, B.R.; et al. Heavy Metal (Arsenic) Induced Antibiotic Resistance among Extended-Spectrum β-Lactamase (ESBL) Producing Bacteria of Nosocomial Origin. Pharmaceuticals 2022, 15, 1426. https://doi.org/10.3390/ph15111426
Ahmed N, Tahir K, Aslam S, Cheema SM, Rabaan AA, Turkistani SA, Garout M, Halwani MA, Aljeldah M, Al Shammari BR, et al. Heavy Metal (Arsenic) Induced Antibiotic Resistance among Extended-Spectrum β-Lactamase (ESBL) Producing Bacteria of Nosocomial Origin. Pharmaceuticals. 2022; 15(11):1426. https://doi.org/10.3390/ph15111426
Chicago/Turabian StyleAhmed, Naveed, Kinza Tahir, Sara Aslam, Sara Masood Cheema, Ali A. Rabaan, Safaa A. Turkistani, Mohammed Garout, Muhammad A. Halwani, Mohammed Aljeldah, Basim R. Al Shammari, and et al. 2022. "Heavy Metal (Arsenic) Induced Antibiotic Resistance among Extended-Spectrum β-Lactamase (ESBL) Producing Bacteria of Nosocomial Origin" Pharmaceuticals 15, no. 11: 1426. https://doi.org/10.3390/ph15111426
APA StyleAhmed, N., Tahir, K., Aslam, S., Cheema, S. M., Rabaan, A. A., Turkistani, S. A., Garout, M., Halwani, M. A., Aljeldah, M., Al Shammari, B. R., Sabour, A. A., Alshiekheid, M. A., Alshamrani, S. A., Azmi, R. A., Al-Absi, G. H., Zeb, S., & Yean, C. Y. (2022). Heavy Metal (Arsenic) Induced Antibiotic Resistance among Extended-Spectrum β-Lactamase (ESBL) Producing Bacteria of Nosocomial Origin. Pharmaceuticals, 15(11), 1426. https://doi.org/10.3390/ph15111426

